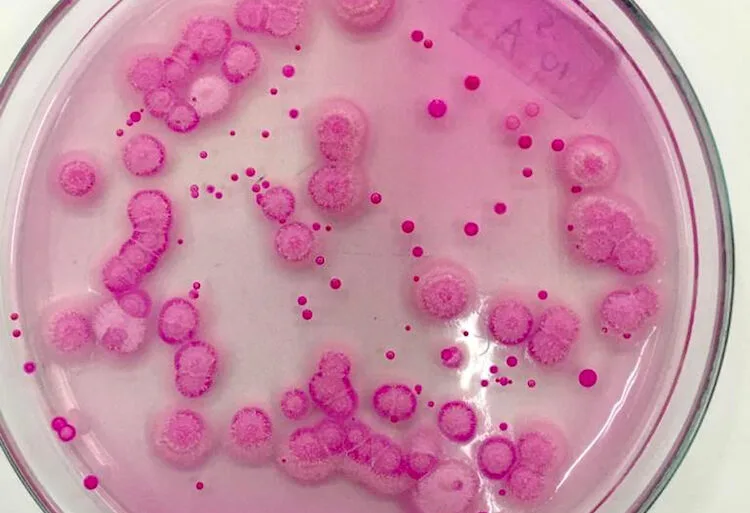

Sim, existe pesquisa! Trecho do livro Guia de Cura de Queijos, que foi baseado em pesquisas científicas realizadas por pesquisadores da Enilbio de Poligny, da França, fala das condições ideais de ambientes para cura. A temperatura exerce uma influência direta na vida microbiana. Para estarem ativos e se reproduzirem no queijo, os microorganismos necessitam, cada […]
Obtenha acesso a esse conteúdo, assine já.